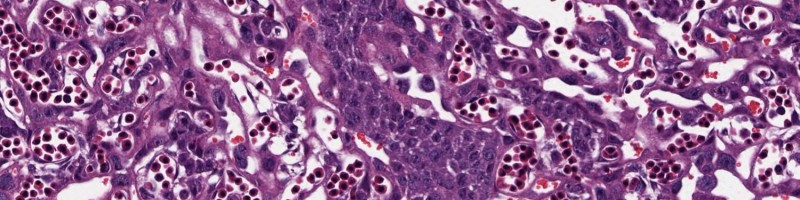

Cariaco Lab
Our research program seeks to redefine the placenta as a dynamic, adaptive sensor that integrates maternal metabolic, inflammatory, and environmental signals to shape fetal development. Moving forward, we aim to uncover how diverse stressors—ranging from obesity and infection to drugs and environmental contaminants—reprogram placental biology and drive lifelong developmental outcomes.
We will advance this vision through the following research directions:
- Mapping placental response networks to complex prenatal exposures
We aim to characterize how the placenta integrates diverse external stressors into coordinated molecular and cellular programs, revealing how exposure-specific signals translate into functional changes in placental biology. In particular, we will define how these signals reshape key processes such as immune signaling, metabolism, and tissue organization, and how their integration ultimately influences placental function and fetal development. - Advancing next-generation AI-powered image analysis and multi-omics integration frameworks
A central innovation of our program is both the development and application of integrative computational tools that unify transcriptomics, proteomics, metabolomics, and pathomics. By moving beyond single-layer analyses, we aim to capture coordinated biological signals across molecular, cellular, and tissue scales. This integrated approach will enable the identification of pathway-level signatures that reflect how placental function is reprogrammed in response to prenatal stressors.
By combining experimental systems, human cohorts, and computational innovation, our program will generate a systems-level understanding of placental biology. Ultimately, we aim to identify actionable pathways that can be targeted to improve fetal growth, protect neurodevelopment, and reduce long-term disease risk.
